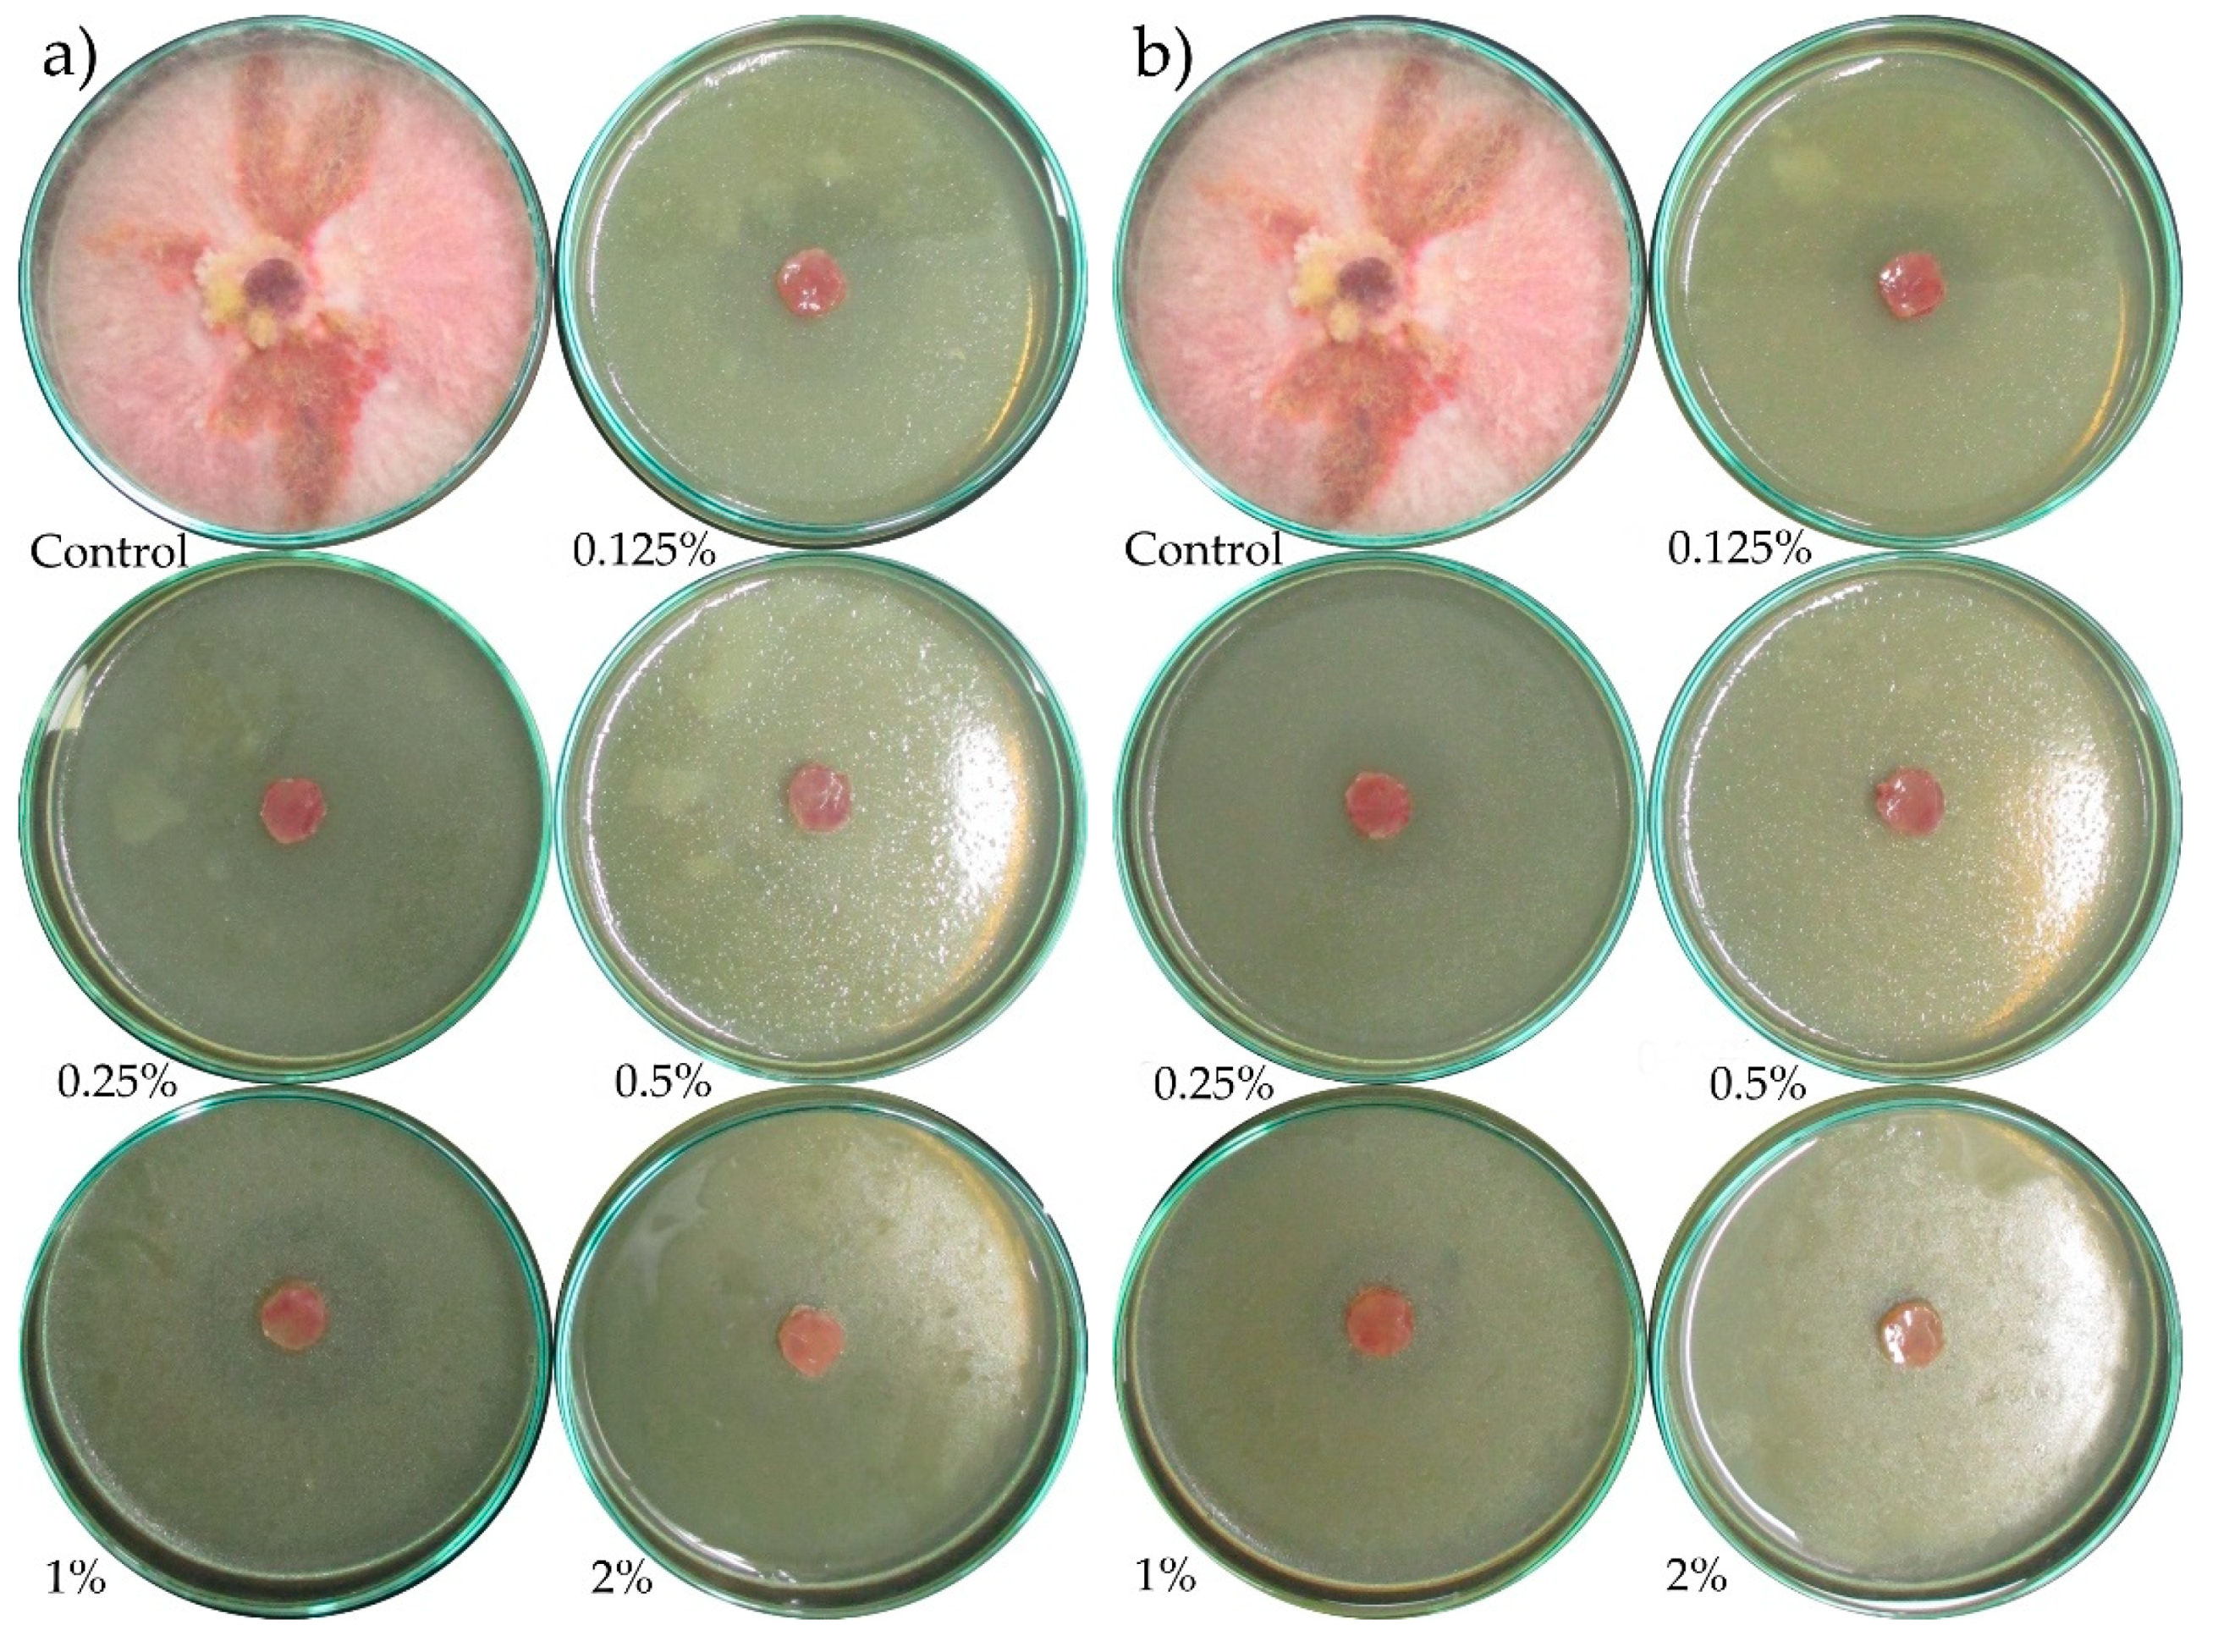
Molecules 24 00311 g0a5
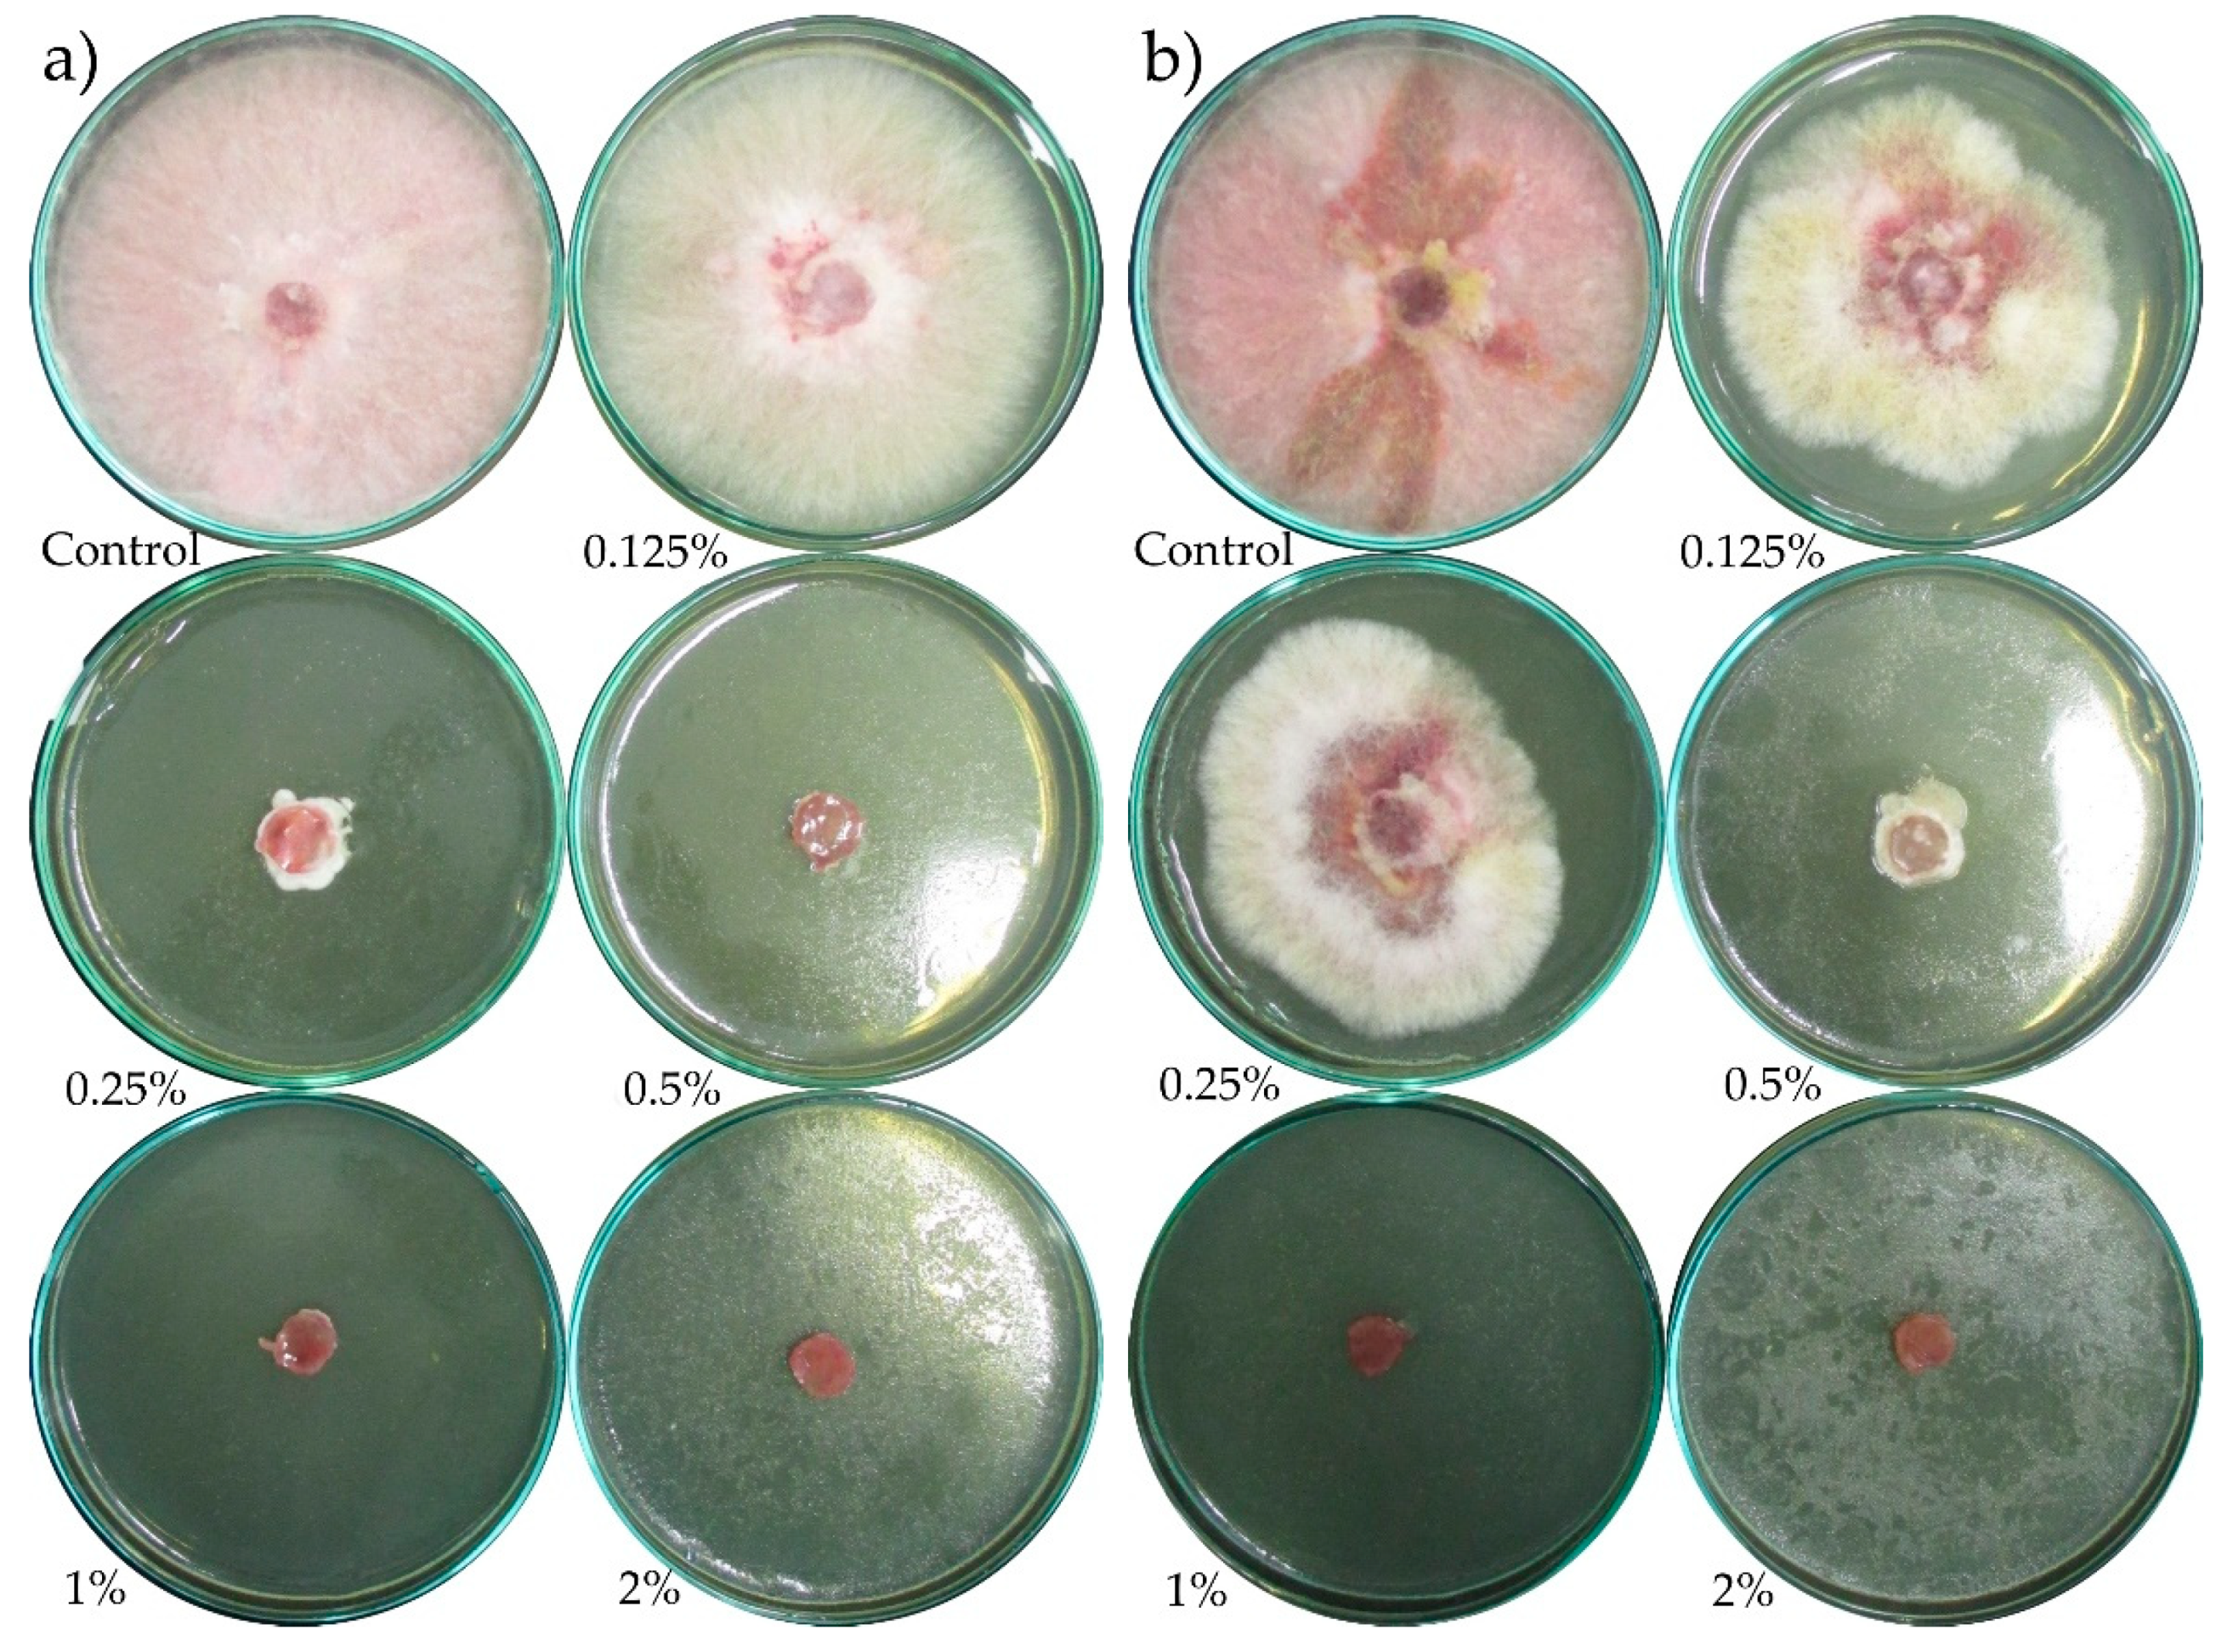
Molecules 24 00311 g0a7

Comparison of the Fungistatic Activity of Selected Essential Oils Relative to Fusarium graminearum Isolates
Abstract
:1. Introduction
2. Results
3. Discussion
4. Materials and Methods
4.1. Materials
4.2. The Gas Chromatography Mass Spectrometry Analysis
4.3. Biological
- T – index of linear growth
- A – average measurement value of diameter colonies (mm)
- D – duration of the experiment
- b1….bx – increase in colonies diameter (mm)
- d1..dx – number of days since last measurement
- I – fungus linear growth inhibition index (%)
- C – fungus colony diameter in the control combination (mm)
- M – fungus colony diameter on a control plate with a given oil in the combination containing a tested substance concentration in the medium [mm]
5. Conclusions
Author Contributions
Conflicts of Interest
Appendix A

References
- Walkowiak, W.; Krzyśko-Łupicka, T. New solution in grain protection against fusariosis. Prog. Plant Prot. 2014, 54, 127–134. [Google Scholar]
- Kordowska-Wiater, M. Yeasts as biological control agents for plants. Post. Mikrobiol. 2011, 50, 107–119. [Google Scholar]
- Nowak, W.; Sowiński, J.; Pietr, S.J.; Kita, W. Influence of methods of winter wheat protection on the quality of consumer grain. Pam. Puł. 2005, 139, 117–127. [Google Scholar]
- Mares, D.; Tosi, B.; Poli, F.; Andreotti, E.; Romagnoli, C. Antifungal activity of Tagetes patula extracts on some phytopathogenic fungi: Ultrastructural evidence on Pythium ultimum. Microbiol. Res. 2004, 159, 295–304. [Google Scholar] [CrossRef] [PubMed]
- Thomas, M.B.; Willis, A.I. Bicontrol-risky but necessary. Tree 1998, 13, 325–329. [Google Scholar] [PubMed]
- Burt, S. Essential oils: Their antibacterial properties and potential applications in foods—A review. Int. J. Food Microbiol. 2004, 94, 223–253. [Google Scholar] [CrossRef] [PubMed]
- Hashem, M.; Moharam, A.M.; Zaied, A.A.; Saleh, F.E.M. Efficacy of essential oils in the control of cumin root rot disease caused by Fusarium spp. Crop Prot. 2010, 29, 1111–1117. [Google Scholar] [CrossRef]
- Orlikowski, L.B. Development and spread of Phytophthora ramorum in the presence of grapefruit extract. J. Plant Prot. Res. 2003, 43, 213–218. [Google Scholar]
- Burgieł, Z.J.; Smagłowski, M. Fungistic properties of tea tree oil. Probl. J. Agric. Sci. 2008, 529, 13–18. [Google Scholar]
- Survilienė, E.; Valiuškaitė, A.; Snieškienė, V.; Stankevičienė, A. Effect of essential oils on fungi isolated from apples and vegetables. Lithuanianinstitute Horticult. Lithuannian Univ. Agric. 2009, 28, 227–234. [Google Scholar]
- Białoń, M.; Krzyśko-Łupicka, T.; Koszałkowska, M.; Wieczorek, P.P. Chemical composition of lemon essential oils and their fungicidal activity against Candida yeasts. Mycopathologia 2014, 177, 29–39. [Google Scholar] [CrossRef] [PubMed]
- Kwaśna, H.; Chełkowski, J.; Zajkowski, P. Poland Flora, Fungi (Mycota), Volume XXII, Sierpik (Fusarium); PAN Publisher: Warsaw-Krakow, Poland, 1991. [Google Scholar]
- Kędzia, A. Antifungal activity of geranium oil (Oleum geranii). Adv. Phytoth. 2009, 4, 217–222. [Google Scholar]
- Cavanagh, H.M.A.; Wilkinson, J.M. Biological Activities of Lavender Essential Oil. Phytother. Res. 2002, 16, 301–308. [Google Scholar] [CrossRef] [PubMed]
- Bakkali, F.; Averbeck, S.; Averbeck, D.; Idaomar, M. Biological effects of essential oils—A review. Food Chem. Toxicol. 2008, 46, 446–475. [Google Scholar] [CrossRef]
- Sienkiewicz, M.; Kalemba, D.; Wasiela, M. The evaluation of the sensitivity of clinical strains of Escherichia coli to the action of thyme and lavender oil in relation to their drug resistance. Med. Exp. Microbiol. 2011, 63, 273–281. [Google Scholar]
- Viuda-Martos, M.; Ruiz-Navajas, Y.; Fernaández-López, J.; Pêrez-Ălvarez, J. Antifungal activity of lemon (Citrus lemon L.), mandarin (Citrus reticulata L.), grapefruit (Citrus paradisi L.) and orange (Citrus sinensis L.) essential oils. Food Control 2007, 19, 1130–1138. [Google Scholar] [CrossRef]
- Dimitra, J.D.; Basil, N.Z.; Moschos, G.P. The effectiveness of plant essential oils on the growth of Botrytis cinerea, Fusarium sp. and Clavibacter michiganensis subsp. michiganensis. Crop Prot. 2003, 22, 39–44. [Google Scholar] [CrossRef]
- Te, Z.; Fei, G.; Lin, Z.; Tian-you, S. Essential Oil from Inula britannica extraction with SF-CO2 and its antifungal activity. J. Integr. Agric. 2013, 12, 1791–1798. [Google Scholar] [CrossRef]
- Riccioni, L.; Orzali, L. Activity of Tea Tree (Melaleuca alternifolia, Cheel) and thyme (Thymus vulgaris, Linnaeus.) Essential Oils against Some Pathogenic Seed Borne Fungi. J. Essent. Oil Res. 2011, 23, 43–47. [Google Scholar] [CrossRef]
- Amini, M.; Safaie, N.; Salmani, M.J.; Shams-Baksh, M. Antifungal activity of three medicinal plant essential oils against some phytopathogenic fungi. Trakia J. Sci. 2012, 10, 1–8. [Google Scholar]
- Samie, A.; Nefefe, T. Antifungal activities of essential oils from Southern African medicinal plants against five Fusarium species. J. Med. Plant. Res. 2012, 6, 465–478. [Google Scholar]
- Krifa, M.; Gharad, T.; Haouala, R. Biological activities of essential oil, aqueous and organic extracts of Pituranthos tortuosus (Coss.) Maire. Sci. Hort. 2010, 128, 61–67. [Google Scholar] [CrossRef]
- Simić, A.; Soković, M.D.; Ristić, M.; Grujić-Jovanović, S.; Vukojević, J.; Marin, P.D. The Chemical Composition of some Lauraceae Essential Oils and Their Antifungal Activities. Phytother. Res. 2004, 18, 713–717. [Google Scholar] [CrossRef] [PubMed]
- Abdel-Kader, M.; El-Mougy, S.; Lashin, S. Essentials oils and Trichoderma harzianum as an integrated control measure against faba bean root rot pathogens. J. Plant Prot. Res. 2011, 51, 306–313. [Google Scholar] [CrossRef]
- Khirsagar, R.P.; Kothamasu, M.V.; Patil, M.A.; Reddy, B.G.; Kumar, B.D.; Diwan, P.V. Geranium oil ameliorates endothelial dysfunction in high fat high sucrose diet induced metabolic complications in rats. J. Funct. Foods 2015, 15, 284–293. [Google Scholar] [CrossRef]
- Ćosić, J.; Vrandečić, K.; Postić, J.; Jurković, D.; Ravlić, M. In vitro antifungal activity of essential oils on growth of phytopathogenic fungi. Poljoprivreda 2010, 16, 25–28. [Google Scholar]
- Gömöri, C.; Nacsa-Farkas, E.; Kerekes, E.B.; Kocsubé, S.; Vágvölgyi, C.; Krisch, J. Evaluation of five essential oils for the control of foodspoilage and mycotoxin producing fungi. Acta Biol. Szeged. 2013, 57, 113–116. [Google Scholar]
- Koshima, C.C.; Capellini, M.C.; Geramias, I.M.; Aracava, K.K.; Gonçalves, C.B.; Rodriques, E.C. Fractionation of lemon essential oil by solvent extraction: Phase equilibrium for model systems at T = 298.2 K. J. Chem. Thermodyn. 2012, 54, 316–332. [Google Scholar] [CrossRef]
- Watanabe, T. Pictorial Atlas of Soil and Seed Fungi: Morphologies of Cultured Fungi and Key to Species, 3rd ed.; CRC Press Taylor & Francis Group: Boca Raton, FL, USA, 2010. [Google Scholar]
- Pląskowska, E. Characteristics and taxonomy of fungi of the genus Fusarium. Med. Mycol. 2010, 17, 172–176. [Google Scholar]
- Barbiel, M. In vitro of Didymella bryoniae, Fusarium oxysporum, Trichoderma spp. In Sclerotium rolfsii and Thielaviopsis basicola to the Botanical Fungicide Timorex Gold (Melaleuca alternifolia) under the Paper Disk Diffusion and the Poisoning Agar Testing Methods; University of Florida-IFAS, Plant Medicine Program, Gainesville, Marcel Barbier: Gainesville, FL, USA, 2012. [Google Scholar]
- Gleń, K.; Boligłowa, E. The effect of extracts from herbal plants on dominating species of fungi colonizing broad bean seeds. J. Res. Appl. Agric. Eng. 2012, 57, 98–103. [Google Scholar]
Sample Availability: Samples of the compounds are not available from the authors. |


| Area (%) of Terpenes in Etja Essential Oils | ||||
|---|---|---|---|---|
| Lemon | Rosewood | Geranium | Rosemary | |
| monoterpenes | 85.70 | 0.75 | 8.09 | 35.27 |
| oxygenated monoterpenes | 13.76 | 96.75 | 88.17 | 52.76 |
| sesquiterpenes | - | - | 1.17 | 11.54 |
| oxygenated sesquiterpenes | - | 0.95 | 1.34 | 0.30 |
| IR | Area (%) ± SD of Components in Etja Essential Oils | ||||
|---|---|---|---|---|---|
| Lemon | Rosewood | Geranium | Rosemary | ||
| MONOTERPENES | |||||
| tricyclene | 919 | 0.21 ± 0.04 | - | - | 0.48 ± 0.03 |
| α-pinene | 930 | 11.06 ± 0.14 | - | 0.05 ± 0.01 | 10.33 ± 0.03 |
| camphene | 946 | 0.35 ± 0.04 | - | 0.04 ± 0.01 | 8.18 ± 0.03 |
| β-citronellene | 948 | - | 0.02 ± 0.01 | - | - |
| β-thujene | 970 | - | - | - | 3.92 ± 0.20 |
| β-pinene | 973 | 15.14 ± 0.04 | - | 0.03 ± 0.01 | 7.62 ± 0.14 |
| 2,6-dimethyl-2,6-octadiene | 980 | - | - | 0.45 ± 0.01 | - |
| 3-menthene | 981 | - | - | 0.26 ± 0.02 | - |
| β-myrcene | 984 | 4.11 ± 0.06 | - | - | 1.72 ± 0.03 |
| 2-carene | 996 | - | - | 0.05 ± 0.01 | - |
| α-phellandrene | 999 | - | - | - | 0.11 ± 0.02 |
| α-terpinene | 1016 | 0.40 ± 0.12 | - | - | 0.06 ± 0.01 |
| p-cymene | 1019 | - | - | 0.19 ± 0.01 | - |
| limonene | 1024 | 48.27 ± 0.05 | 0.73 ± 0.02 | 6.86 ± 0.05 | - |
| trans-β-ocimene | 1040 | 0.13 ± 0.03 | - | - | - |
| α-ocimene | 1050 | - | - | 0.01 ± 0.01 | - |
| β-terpinene | 1053 | - | - | 0.01 ± 0.01 | - |
| γ-terpinene | 1059 | 4.85 ± 0.06 | - | - | 2.16 ± 0.02 |
| terpinolene | 1077 | 1.19 ± 0.03 | - | - | 0.68 ± 0.02 |
| Sum | - | 85.70 | 0.75 | 8.09 | 35.27 |
| OXYGENATED MONOTERPENES | |||||
| eucalyptol | 1030 | - | 1.55 ± 0.04 | - | 15.87 ± 0.12 |
| dehydrolinalool | 1072 | - | 0.11 ± 0.01 | - | - |
| cis-linalool oxide | 1073 | - | 2.07 ± 0.03 | 0.05 ± 0.01 | - |
| rose oil | 1087 | - | - | 3.05 ± 0.04 | - |
| trans-linalool oxide | 1089 | - | 1.56 ± 0.03 | 0.07 ± 0.01 | - |
| cis rose oxide | 1096 | - | - | 0.20 ± 0.01 | - |
| linalool | 1099 | 0.29 ± 0.06 | 79.51 ± 0.32 | 11.27 ± 0.06 | 1.83 ± 0.06 |
| myrcenol | 1099 | - | 0.06 ± 0.01 | - | - |
| trans rose oxide | 1113 | - | - | 0.09 ± 0.01 | - |
| 1-terpineol | 1121 | - | - | 0.05 ± 0.01 | - |
| α-pinene oxide | 1126 | 0.17 ± 0.02 | - | - | - |
| menthone | 1133 | - | - | 0.59 ± 0.02 | - |
| camphor | 1141 | - | - | - | 16.00 ± 0.11 |
| α-phellandren-8-ol | 1144 | - | 0.01 ± 0.01 | - | - |
| isomenthone | 1144 | - | - | 0.53 ± 0.03 | - |
| isoborneol | 1145 | - | - | 0.32 ± 0.01 | - |
| isopulegol | 1149 | - | - | 0.33 ± 0.01 | - |
| verbenol | 1154 | 0.08 ± 0.01 | - | - | - |
| menthol | 1164 | 0.12 ± 0.01 | - | - | - |
| borneol | 1168 | - | - | 0.49 ± 0.01 | 7.95 ± 0.10 |
| lavandulol | 1171 | - | 1.72 ± 0.01 | - | - |
| terpinen-4-ol | 1174 | - | - | - | 1.43 ± 0.03 |
| γ-terpineol | 1185 | - | - | 0.32 ± 0.03 | - |
| α-terpineol | 1197 | - | 8.27 ± 0.01 | 1.53 ± 0.03 | 5.62 ± 0.12 |
| fenchol | 1199 | - | - | - | 0.08 ± 0.01 |
| α-fenchyl acetate | 1202 | - | - | - | 0.50 ± 0.05 |
| linalyl formate | 1205 | - | - | 2.81 ± 0.09 | - |
| β-citronellol | 1208 | - | - | 30.99 ± 0.20 | - |
| α-citronellol | 1209 | 0.20 ± 0.02 | - | 4.73 ± 0.23 | - |
| nerol | 1232 | - | 1.64 ± 0.02 | - | - |
| geraniol | 1233 | - | - | 17.20 ± 0.10 | - |
| α-citral | 1247 | 7.14 ± 0.07 | 0.08 ± 0.01 | 0.32 ± 0.03 | - |
| 2,6-dimethyl-1,7-octadiene-3,6-diol | 1268 | - | 0.07 ± 0.01 | - | - |
| borneol acetate | 1270 | - | - | - | 3.47 ± 0.03 |
| β-citral | 1278 | 4.30 ± 0.14 | 0.05 ± 0.01 | 0.25 ± 0.11 | - |
| geranyl formate | 1294 | 0.91 ± 0.01 | - | 0.62 ± 0.03 | - |
| citronellol acetate | 1338 | - | - | 0.35 ± 0.01 | - |
| p-mentha-1-en-3,8-diol | 1351 | - | 0.03 ± 0.01 | - | - |
| neryl acetate | 1364 | 0.49 ± 0.06 | - | 0.51 ± 0.01 | - |
| geranyl acetate | 1383 | - | - | 8.56 ± 0.22 | - |
| cis-geranylacetone | 1418 | - | - | 0.17 ± 0.01 | - |
| carvone hydrate | 1427 | - | 0.02 ± 0.01 | - | - |
| citronellyl propionate | 1431 | - | - | 0.33 ± 0.02 | - |
| geranyl propionate | 1451 | - | - | 0.10 ± 0.01 | - |
| geranyl isobutyrate | 1494 | - | - | 0.70 ± 0.01 | - |
| geranyl butyrate | 1542 | - | - | 1.22 ± 0.03 | - |
| citronellyl tiglate | 1646 | - | - | 0.30 ± 0.03 | - |
| geranyl tiglate | 1657 | - | - | 0.12 ± 0.01 | - |
| sum | - | 13.76 | 96.75 | 88.17 | 52.76 |
| SESQUITERPENES | |||||
| α-cubebene | 1354 | - | - | - | 0.16 ± 0.01 |
| α-longipinene | 1359 | - | - | - | 0.07 ± 0.01 |
| α-copaene | 1379 | - | - | 0.03 ± 0.01 | 0.57 ± 0.02 |
| β-cubebene | 1384 | - | - | - | 0.20 ± 0.05 |
| β-bourbonene | 1388 | - | - | 0.10 ± 0.02 | - |
| y-langene | 1388 | - | - | - | 0.15 ± 0.02 |
| γ-maaliene | 1398 | - | - | 0.03 ± 0.01 | - |
| aristolene | 1402 | - | - | 0.38 ± 0.02 | - |
| longifolene | 1421 | - | - | 0.05 ± 0.00 | 0.57 ± 0.01 |
| caryophyllene | 1423 | - | - | 0.11 ± 0.01 | 7.58 ± 0.03 |
| alloaromadendrene | 1426 | - | - | 0.05 ± 0.01 | - |
| calarene | 1436 | - | - | 0.16 ± 0.01 | - |
| aromadendrene | 1443 | - | - | - | 0.08 ± 0.01 |
| humulene | 1452 | - | - | - | 1.36 ± 0.08 |
| ledene | 1470 | - | - | 0.22 ± 0.01 | - |
| γ-muurolene | 1479 | - | - | - | 0.11 ± 0.01 |
| isocaryophyllene | 1495 | - | - | - | 0.04 ± 0.01 |
| γ-cadinene | 1503 | - | - | - | 0.29 ± 0.03 |
| δ-selinene | 1510 | - | - | 0.04 ± 0.01 | - |
| δ-cadinene | 1525 | - | - | - | 0.37 ± 0.02 |
| Sum | - | - | - | 1.17 | 11.54 |
| OXYGENATED SESQUITERPENES | |||||
| elemol | 1535 | - | - | 0.03 ± 0.01 | - |
| nerolidol | 1540 | - | 0.11 ± 0.01 | - | - |
| cis-nerolidol | 1545 | - | 0.16 ± 0.02 | - | - |
| trans-nerolidol | 1551 | - | 0.68 ± 0.02 | - | - |
| guaiol | 1584 | - | - | 0.47 ± 0.02 | - |
| caryophyllene oxide | 1588 | - | - | - | 0.30 ± 0.02 |
| γ-eudesmol | 1620 | - | - | 0.04 ± 0.01 | - |
| bulnesol | 1650 | - | - | 0.54 ± 0.03 | - |
| methyl abietate | 2175 | - | - | 0.26 ± 0.03 | - |
| Sum | - | 0.95 | 1.34 | 0.30 | |
| Oil Concentration (%) | Etja Essential Oils | ||||
|---|---|---|---|---|---|
| Control | Lemon | Rosewood | Geranium | Rosemary | |
| 0.125 | 85.00 a | 69.00 b | 0.00 f | 0.00 f | 36.67 c |
| 0.25 | 85.00 a | 15.00 de | 0.00 f | 0.00 f | 20.67 d |
| 0.5 | 85.00 a | 0.00 f | 0.00 f | 0.00 f | 7.33 ef |
| 1.0 | 85.00 a | 0.00 f | 0.00 f | 0.00 f | 0.00 f |
| 2.0 | 85.00 a | 0.00 f | 0.00 f | 0.00 f | 0.00 f |
| Oil Concentration (%) | Etja Essential Oils | ||||
|---|---|---|---|---|---|
| Control | Lemon | Rosewood | Geranium | Rosemary | |
| 0.125 | 85.00 a | 59.67 b | 0.00 f | 0.00 f | 54.00 bc |
| 0.25 | 85.00 a | 54.33 b | 0.00 f | 0.00 f | 19.00 de |
| 0.5 | 85.00 a | 35.67 cd | 0.00 f | 0.00 f | 4.17 ef |
| 1.0 | 85.00 a | 0.00 f | 0.00 f | 0.00 f | 0.00 f |
| 2.0 | 85.00 a | 0.00 f | 0.00 f | 0.00 f | 0.00 f |
© 2019 by the authors. Licensee MDPI, Basel, Switzerland. This article is an open access article distributed under the terms and conditions of the Creative Commons Attribution (CC BY) license (http://creativecommons.org/licenses/by/4.0/).
Share and Cite
Krzyśko-Łupicka, T.; Walkowiak, W.; Białoń, M. Comparison of the Fungistatic Activity of Selected Essential Oils Relative to Fusarium graminearum Isolates. Molecules 2019, 24, 311. https://doi.org/10.3390/molecules24020311
Krzyśko-Łupicka T, Walkowiak W, Białoń M. Comparison of the Fungistatic Activity of Selected Essential Oils Relative to Fusarium graminearum Isolates. Molecules. 2019; 24(2):311. https://doi.org/10.3390/molecules24020311
Chicago/Turabian StyleKrzyśko-Łupicka, Teresa, Weronika Walkowiak, and Marietta Białoń. 2019. "Comparison of the Fungistatic Activity of Selected Essential Oils Relative to Fusarium graminearum Isolates" Molecules 24, no. 2: 311. https://doi.org/10.3390/molecules24020311
APA StyleKrzyśko-Łupicka, T., Walkowiak, W., & Białoń, M. (2019). Comparison of the Fungistatic Activity of Selected Essential Oils Relative to Fusarium graminearum Isolates. Molecules, 24(2), 311. https://doi.org/10.3390/molecules24020311

